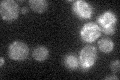
YOR334W
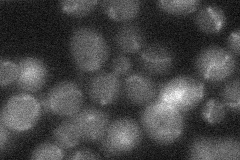
YOR334W
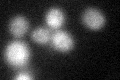
YOR334W
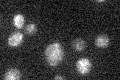
YOR334W

View description
Mitochondrial inner membrane Mg(2+) channel, required for maintenance of intramitochondrial Mg(2+) concentrations at the correct level to support splicing of group II introns
Localization:
Intensity:
Fold change:
Significance:
-
C’ GFP library in SD
mitochondria17.39 -
N' NOP1pr-GFP in SD

mitochondria32.318 -
N' TEF2pr-mCherry in SD

mitochondria5.4469 -
N' NATIVEpr-GFP in SD
mitochondria14.8715 -
N' TEF2pr-VC and Cyto-VN in SD

#N/A0 -
C’ GFP library in SD+DTT
mitochondria16.380.94No -
C’ GFP library in SD+H2O2

mitochondria16.620.95No -
C’ GFP library in Starvation Media
mitochondria17.61.01No -
C’ GFP library on the background of Pup2-DaMP

mitochondria -
C’ GFP library on the background of CCT mutant

mitochondria17.03070.978939No
